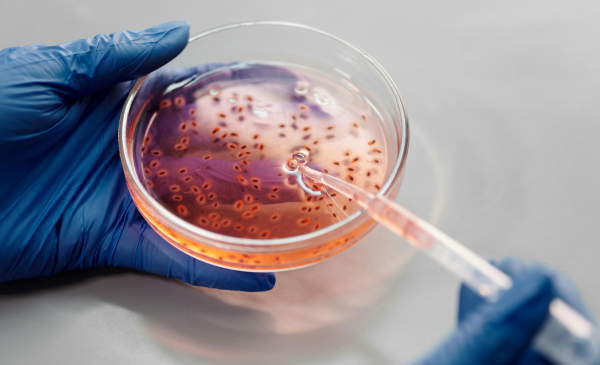

Resistencia a los antimicrobianos, no resistencia antimicrobiana, es la opción preferible para referirse a la capacidad de los microorganismos para eludir la acción de los medicamentos que actúan en su contra.
Sin embargo, en los medios de comunicación, a menudo se encuentran frases como «La ONU considera que la resistencia antimicrobiana es una de las 10 principales amenazas a las que se enfrenta la humanidad», «Estamos en un tiempo de la historia muy peligroso porque la resistencia antimicrobiana aumenta» o «La ministra de Sanidad ha subrayado que el incremento de las resistencias antimicrobianas requiere de un compromiso político».
El Diccionario panhispánico de términos médicos desaconseja el uso de resistencia antimicrobiana, pues lo considera confuso, y remite a resistencia a los antimicrobianos, que es la ‘capacidad, natural o adquirida, de un microorganismo para resistirse a la acción de uno o varios fármacos antimicrobianos’. Como equivalente de esta expresión puede emplearse resistencia microbiana.
Por tanto, en los ejemplos citados habría sido más apropiado escribir «La ONU considera que la resistencia a los antimicrobianos es una de las 10 principales amenazas a las que se enfrenta la humanidad», «Estamos en un tiempo de la historia muy peligroso porque la resistencia a los antimicrobianos aumenta» y «La ministra de Sanidad ha subrayado que el incremento de las resistencias a los antimicrobianos requiere de un compromiso político».
Cabe recordar que, aunque a veces se recurra a las siglas AMR, del inglés antimicrobial resistance, para citar este fenómeno, es más adecuado utilizar su traducción al español, RAM.